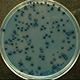
Xenorhabdus spp. primary form bacteria on agar plate (J. Christen)

Division of
Nematodes
photo galleries
Meetings
- Nematodes Home
- Officers
- Minutes
- 2012 (pdf)
- Activities/Resources
- Awards & Honors
- Archives
- Photo Galleries